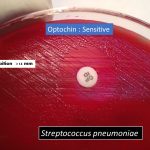
optochin susceptibility test

Tag: use of optochin
Optochin Susceptibility Test :Principle, Procedure, Result and Interpretation
Optochin Susceptibility Test Optochin Susceptibility test uses for presumptive identification...
Optochin Susceptibility Test Optochin Susceptibility test uses for presumptive identification...
Use of Optochin in Blood Agar during Sputum Inoculation: Introduction, Principle and Procedure
 Introduction of Optochin Sensitivity Test Use of optochin sensitivity test in...
Introduction of Optochin Sensitivity Test Use of optochin sensitivity test in...
Diagnostic Antimicrobial Agents: Introduction, Working Mechanism and Uses
 Diagnostic antimicrobial agents(Antibiotics) There are some diagnostic antimicrobial agents that...
Diagnostic antimicrobial agents(Antibiotics) There are some diagnostic antimicrobial agents that...
